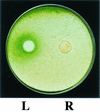

Relationship between secondary metabolism and fungal development
- PMID: 12208999
- PMCID: PMC120793
- DOI: 10.1128/MMBR.66.3.447-459.2002
Relationship between secondary metabolism and fungal development
Abstract
Filamentous fungi are unique organisms-rivaled only by actinomycetes and plants-in producing a wide range of natural products called secondary metabolites. These compounds are very diverse in structure and perform functions that are not always known. However, most secondary metabolites are produced after the fungus has completed its initial growth phase and is beginning a stage of development represented by the formation of spores. In this review, we describe secondary metabolites produced by fungi that act as sporogenic factors to influence fungal development, are required for spore viability, or are produced at a time in the life cycle that coincides with development. We describe environmental and genetic factors that can influence the production of secondary metabolites. In the case of the filamentous fungus Aspergillus nidulans, we review the only described work that genetically links the sporulation of this fungus to the production of the mycotoxin sterigmatocystin through a shared G-protein signaling pathway.
Figures

References
-
- Abdollahi, A., and R. L. Buchanan. 1981. Regulation of aflatoxin biosynthesis: characterization of glucose as an apparent inducer of aflatoxin production. J. Food Sci. 46:143-146.
-
- Adams, T. H., M. T. Boylan, and W. E. Timberlake. 1988. brlA is necessary and sufficient to direct conidiophore development in Aspergillus nidulans. Cell 54:353-362. - PubMed
-
- Adams, T. H., and J.-H. Yu. 1998. Coordinate control of secondary metabolite production and asexual sporulation in Aspergillus nidulans. Curr. Opin. Microbiol. 1:674-677. - PubMed
Publication types
MeSH terms
Substances
LinkOut - more resources
Full Text Sources
Other Literature Sources
Medical

